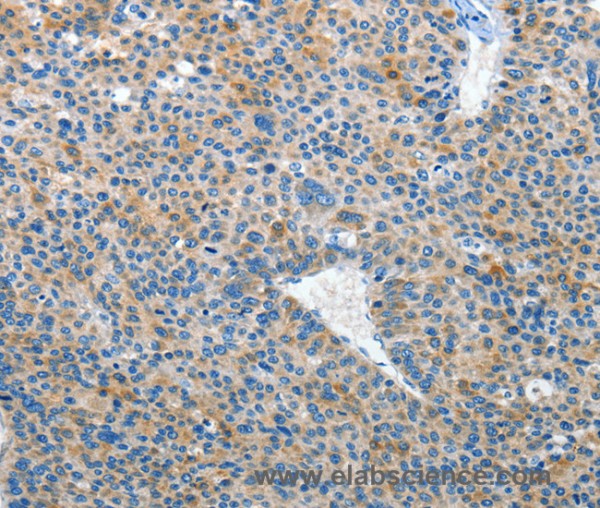
Anti-EPHB3

Cookie preferences
This website uses cookies, which are necessary for the technical operation of the website and are always set. Other cookies, which increase the comfort when using this website, are used for direct advertising or to facilitate interaction with other websites and social networks, are only set with your consent.
Configuration
Technically required
These cookies are necessary for the basic functions of the shop.
"Allow all cookies" cookie
"Decline all cookies" cookie
CSRF token
Cookie preferences
Currency change
Customer-specific caching
FACT-Finder tracking
Individual prices
Selected shop
Session
Comfort functions
These cookies are used to make the shopping experience even more appealing, for example for the recognition of the visitor.
Note
Show the facebook fanpage in the right blod sidebar
Statistics & Tracking
Affiliate program
Conversion and usertracking via Google Tag Manager
Track device being used
If you have any questions, please use our Contact Form.
You can also order by e-mail: info@biomol.com
Larger quantity required? Request bulk
You can also order by e-mail: info@biomol.com
Larger quantity required? Request bulk
Ephrin receptors and their ligands, the ephrins, mediate numerous developmental processes,... more
Product information "Anti-EPHB3"
Ephrin receptors and their ligands, the ephrins, mediate numerous developmental processes, particularly in the nervous system. Based on their structures and sequence relationships, ephrins are divided into the ephrin-A (EFNA) class, which are anchored to the membrane by a glycosylphosphatidylinositol linkage, and the ephrin-B (EFNB) class, which are transmembrane proteins. The Eph family of receptors are divided into two groups based on the similarity of their extracellular domain sequences and their affinities for binding ephrin-A and ephrin-B ligands. Ephrin receptors make up the largest subgroup of the receptor tyrosine kinase (RTK) family. This gene encodes a receptor for ephrin-B family members. Protein function: Receptor tyrosine kinase which binds promiscuously transmembrane ephrin-B family ligands residing on adjacent cells, leading to contact-dependent bidirectional signaling into neighboring cells. The signaling pathway downstream of the receptor is referred to as forward signaling while the signaling pathway downstream of the ephrin ligand is referred to as reverse signaling. Generally has an overlapping and redundant function with EPHB2. Like EPHB2, functions in axon guidance during development regulating for instance the neurons forming the corpus callosum and the anterior commissure, 2 major interhemispheric connections between the temporal lobes of the cerebral cortex. In addition to its role in axon guidance plays also an important redundant role with other ephrin-B receptors in development and maturation of dendritic spines and the formation of excitatory synapses. Controls other aspects of development through regulation of cell migration and positioning. This includes angiogenesis, palate development and thymic epithelium development for instance. Forward and reverse signaling through the EFNB2/EPHB3 complex also regulate migration and adhesion of cells that tubularize the urethra and septate the cloaca. Finally, plays an important role in intestinal epithelium differentiation segregating progenitor from differentiated cells in the crypt. [The UniProt Consortium]
| Keywords: | Anti-EK2, Anti-ETK2, Anti-hEK2, Anti-EPHB3, EC=2.7.10.1, Anti-EPH-like kinase 2, Anti-Embryonic kinase 2, Anti-Ephrin type-B receptor 3, Anti-EPH-like tyrosine kinase 2, Anti-Tyrosine-protein kinase TYRO6, EPHB3 Polyclonal Antibody |
| Supplier: | Elabscience |
| Supplier-Nr: | E-AB-15955 |
Properties
| Application: | IHC, ELISA |
| Antibody Type: | Polyclonal |
| Conjugate: | No |
| Host: | Rabbit |
| Species reactivity: | human, mouse |
| Immunogen: | Synthetic peptide of human EPHB3 |
| Format: | Purified |
Database Information
| KEGG ID : | K05112 | Matching products |
| UniProt ID : | P54753 | Matching products |
| Gene ID : | GeneID 2049 | Matching products |
Handling & Safety
| Storage: | -20°C |
| Shipping: | 4°C (International: -20°C) |
Caution
Our products are for laboratory research use only: Not for administration to humans!
Our products are for laboratory research use only: Not for administration to humans!
Information about the product reference will follow.
more
You will get a certificate here
Viewed



